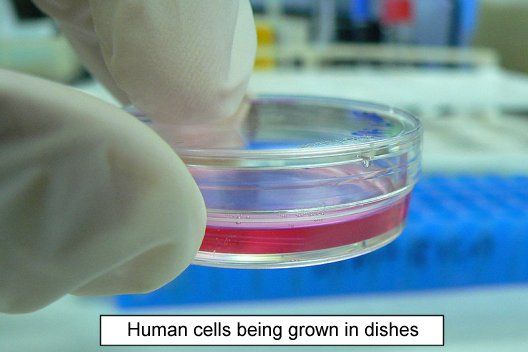

Our life in this world is so tied up with death that our mortality has become a secret shadow that stalks us all our lives. It is the subject that no one discusses in polite conversation, but we all have a funeral at the back of our minds…our funeral.

The resurrection of Jesus of Nazareth brings into the open and public gaze the reality of immortality…but can we really believe in it? Is it real? It is hard for us to believe in the reality of immortality.
One aspect of our lives in this death-dominated world which points towards the reality of immortality is the existence of what are called ‘immortal cells’.
The abnormality of cancer can result in cells that escape the normal restrictions of a limited lifespan.
Even in our present bodily existence, so bound up with death, there is potential for so much more life than the ‘three score years and ten’ of life that we have become used to. The early chapters of Genesis tell us that the human lifespan was for a while much greater than it is now. Even in our current, fallen, death-imprisoned bodies there is potential for immortality!
It is possible to grow human cells outside of the human body in what is called ‘cell culture’. The cells grow in little dishes covered with a liquid and you can even watch them divide through a microscope.

In the 1950s George Gey began growing some cells from a tumour removed from a lady called Henrietta Lacks. The cells (called HeLa cells) grew in the dishes very well. They form what is called an ‘immortal cell line.’
They just keep on growing and dividing without stopping…apparently forever! Hela cells are used today all over the world in medical research and for test purposes.
In a recent book a calculation was made as to the total quantity of these cells if they had all been left to grow since the day that they first started growing outside of Henrietta Lack’s body. The result of the calculation was that there would be 50 million tonnes of her cells! The same weight as 100 Empire State buildings!
Immortality is not a fairy story. It is a solid biological reality. Jesus Christ has conquered all the biological details of mortality and brought immortality to light.
For all who belong to Christ death is not an inevitable and inescapable finality but a short pause before being swallowed by his glorious and real immortal life!